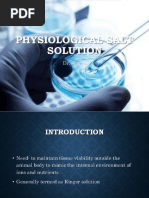

0% found this document useful (0 votes)
1K views23 pagesTablets: Types
Tablets are solid oral dosage forms made by compressing powders into solid units. There are several types of tablets classified by their route of administration and function, including orally ingested tablets, tablets used in the oral cavity, and tablets administered by other routes. Tablets contain active drug ingredients mixed with excipients and are produced through processes like wet and dry granulation to improve properties like flow, reduce dust, and aid compression.
Uploaded by
dadadCopyright
© © All Rights Reserved
We take content rights seriously. If you suspect this is your content, claim it here.
Available Formats
Download as PDF, TXT or read online on Scribd
0% found this document useful (0 votes)
1K views23 pagesTablets: Types
Tablets are solid oral dosage forms made by compressing powders into solid units. There are several types of tablets classified by their route of administration and function, including orally ingested tablets, tablets used in the oral cavity, and tablets administered by other routes. Tablets contain active drug ingredients mixed with excipients and are produced through processes like wet and dry granulation to improve properties like flow, reduce dust, and aid compression.
Uploaded by
dadadCopyright
© © All Rights Reserved
We take content rights seriously. If you suspect this is your content, claim it here.
Available Formats
Download as PDF, TXT or read online on Scribd
/ 23